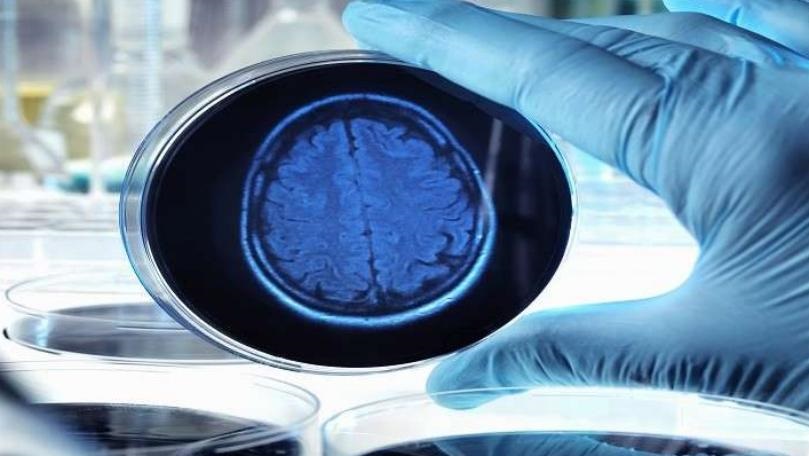
الصيام يساعد في علاج هذا الداء

ما الذي يحدث في الجسم عند تناول ثلاث بيضات في اليوم
ما لا تعرفونه عن الفليفلة...
مؤتمر طبي عن الجديد في معالجة الجلطات الدماغية والصرع

افتتحت إدارة مستشفى المشرق في سن الفيل، المؤتمر الطبي الذي تنظمه ضمن إطار نشاطات سبت المشرق، بعنوان "الجديد في معالجة انسداد الشرايين الدماغية، والاضطربات العصبية والصرع، وأحدث التقنيات في العلاج الجراحي"، بالتعاون مع الجمعية اللبنانية لاطباء الدماغ والاعصاب، في قاعة المؤتمرات في المستشفى، في حضور عدد من الأطباء الاخصائيين من فرنسا ولبنان.


 12-3-2018
12-3-2018 661
661